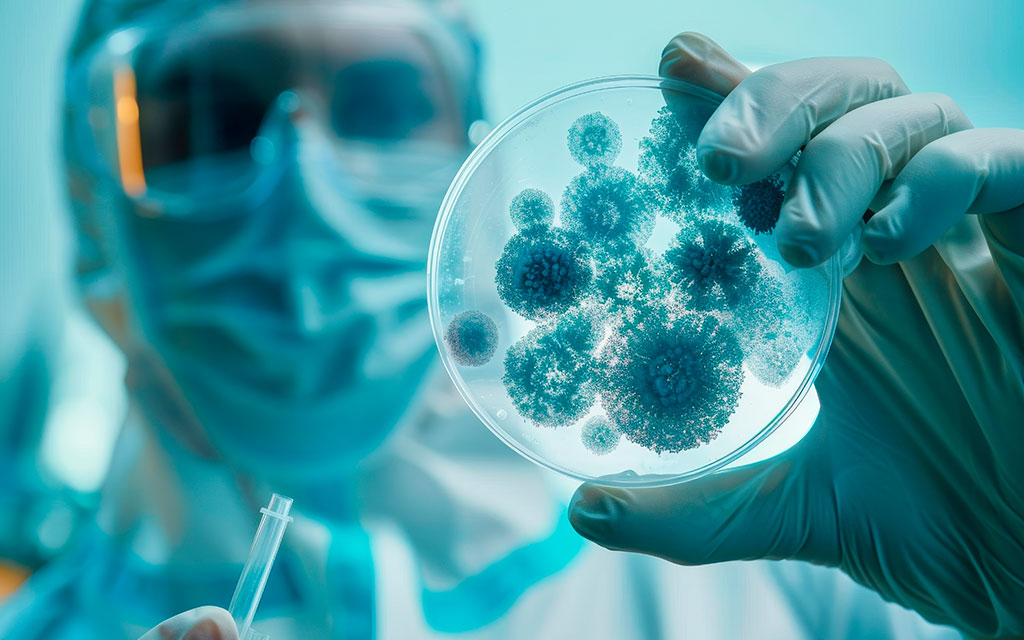
Productos Biológicos

la empresa
Productos de especialidad High Tech para el mercado de exportación. Soluciones ambientalmente amigables que maximizan la rentabilidad de tu negocio.
SOBRE NS GROUP BIOSCIENCE
Nacimos en 2020 para revolucionar el mercado de nutrición vegetal con productos de especialidad y alta tecnología.
NUESTRA HISTORIA
NS GROUP nace de la fusión estratégica de tres empresas líderes: Agromega Perú, Nutrifert Chile y Sweet Saaten Seeds, uniendo décadas de experiencia y expertise.
Nos especializamos en suministrar productos denominados de «especialidad o High Tech» para el mercado de nutrición vegetal de exportación, junto con una completa variedad en semillas híbridas de hortalizas y productos biológicos.

Nuestra Misión
Comercializar productos High Tech para la nutrición vegetal, semillas híbridas y soluciones biológicas, ofreciendo alternativas innovadoras que mejoren la calidad y rentabilidad agrícola con productos libres de residuos y ambientalmente responsables.
Nuestra visión
Ser la empresa líder en Latinoamérica en soluciones agrícolas sostenibles e innovadoras, reconocida por nuestro compromiso con la excelencia, la sostenibilidad ambiental y el desarrollo de una agricultura del futuro.
NUESTROS PRODUCTO
Cuatro líneas de productos diseñadas para maximizar el potencial de tu operación agrícola con tecnología de vanguardia.
Tecnología de Vanguardia
Productos desarrollados con los más altos estándares de calidad y respaldados por investigación científica continua.

Nutrición Vegetal
Productos especializados para optimizar el crecimiento y desarrollo de cultivos de exportación.

Insumos para Fabricantes
Materias primas de calidad superior para formuladores de nutrición vegetal.
Productos Biológicos
Soluciones biotecnológicas que potencian la salud y productividad de los cultivos.

Semillas Híbridas
Variedades de hortalizas seleccionadas por su calidad y rendimiento excepcional.
Excelencia Comprobada
CONTACTOS HOLDING

Las Virginias 1045, Rengo, Chile.
Contacto:
(+56) 9 7128 1173
(+56) 9 9164 0931
www.nsgroupbioscience.com

United States 848 Brickell Ave Ste
950 Miami Fl 3313
+1 (786) 885-2185
www.nsgroupbioscience.com

Germán Schereiber Nro. 175 Int.
607 San Isidro – Lima – Perú.
Contacto:
(+51) 9 7752 6265
(+51) 9 0882 9147
(+51) 9 6067 2602
www.agromega.com.pe

Las Virginias 1045, Rengo, Chile.
Contacto:
(+56) 9 7128 1173
(+56) 9 9164 0931
www.nsgroupbioscience.com

